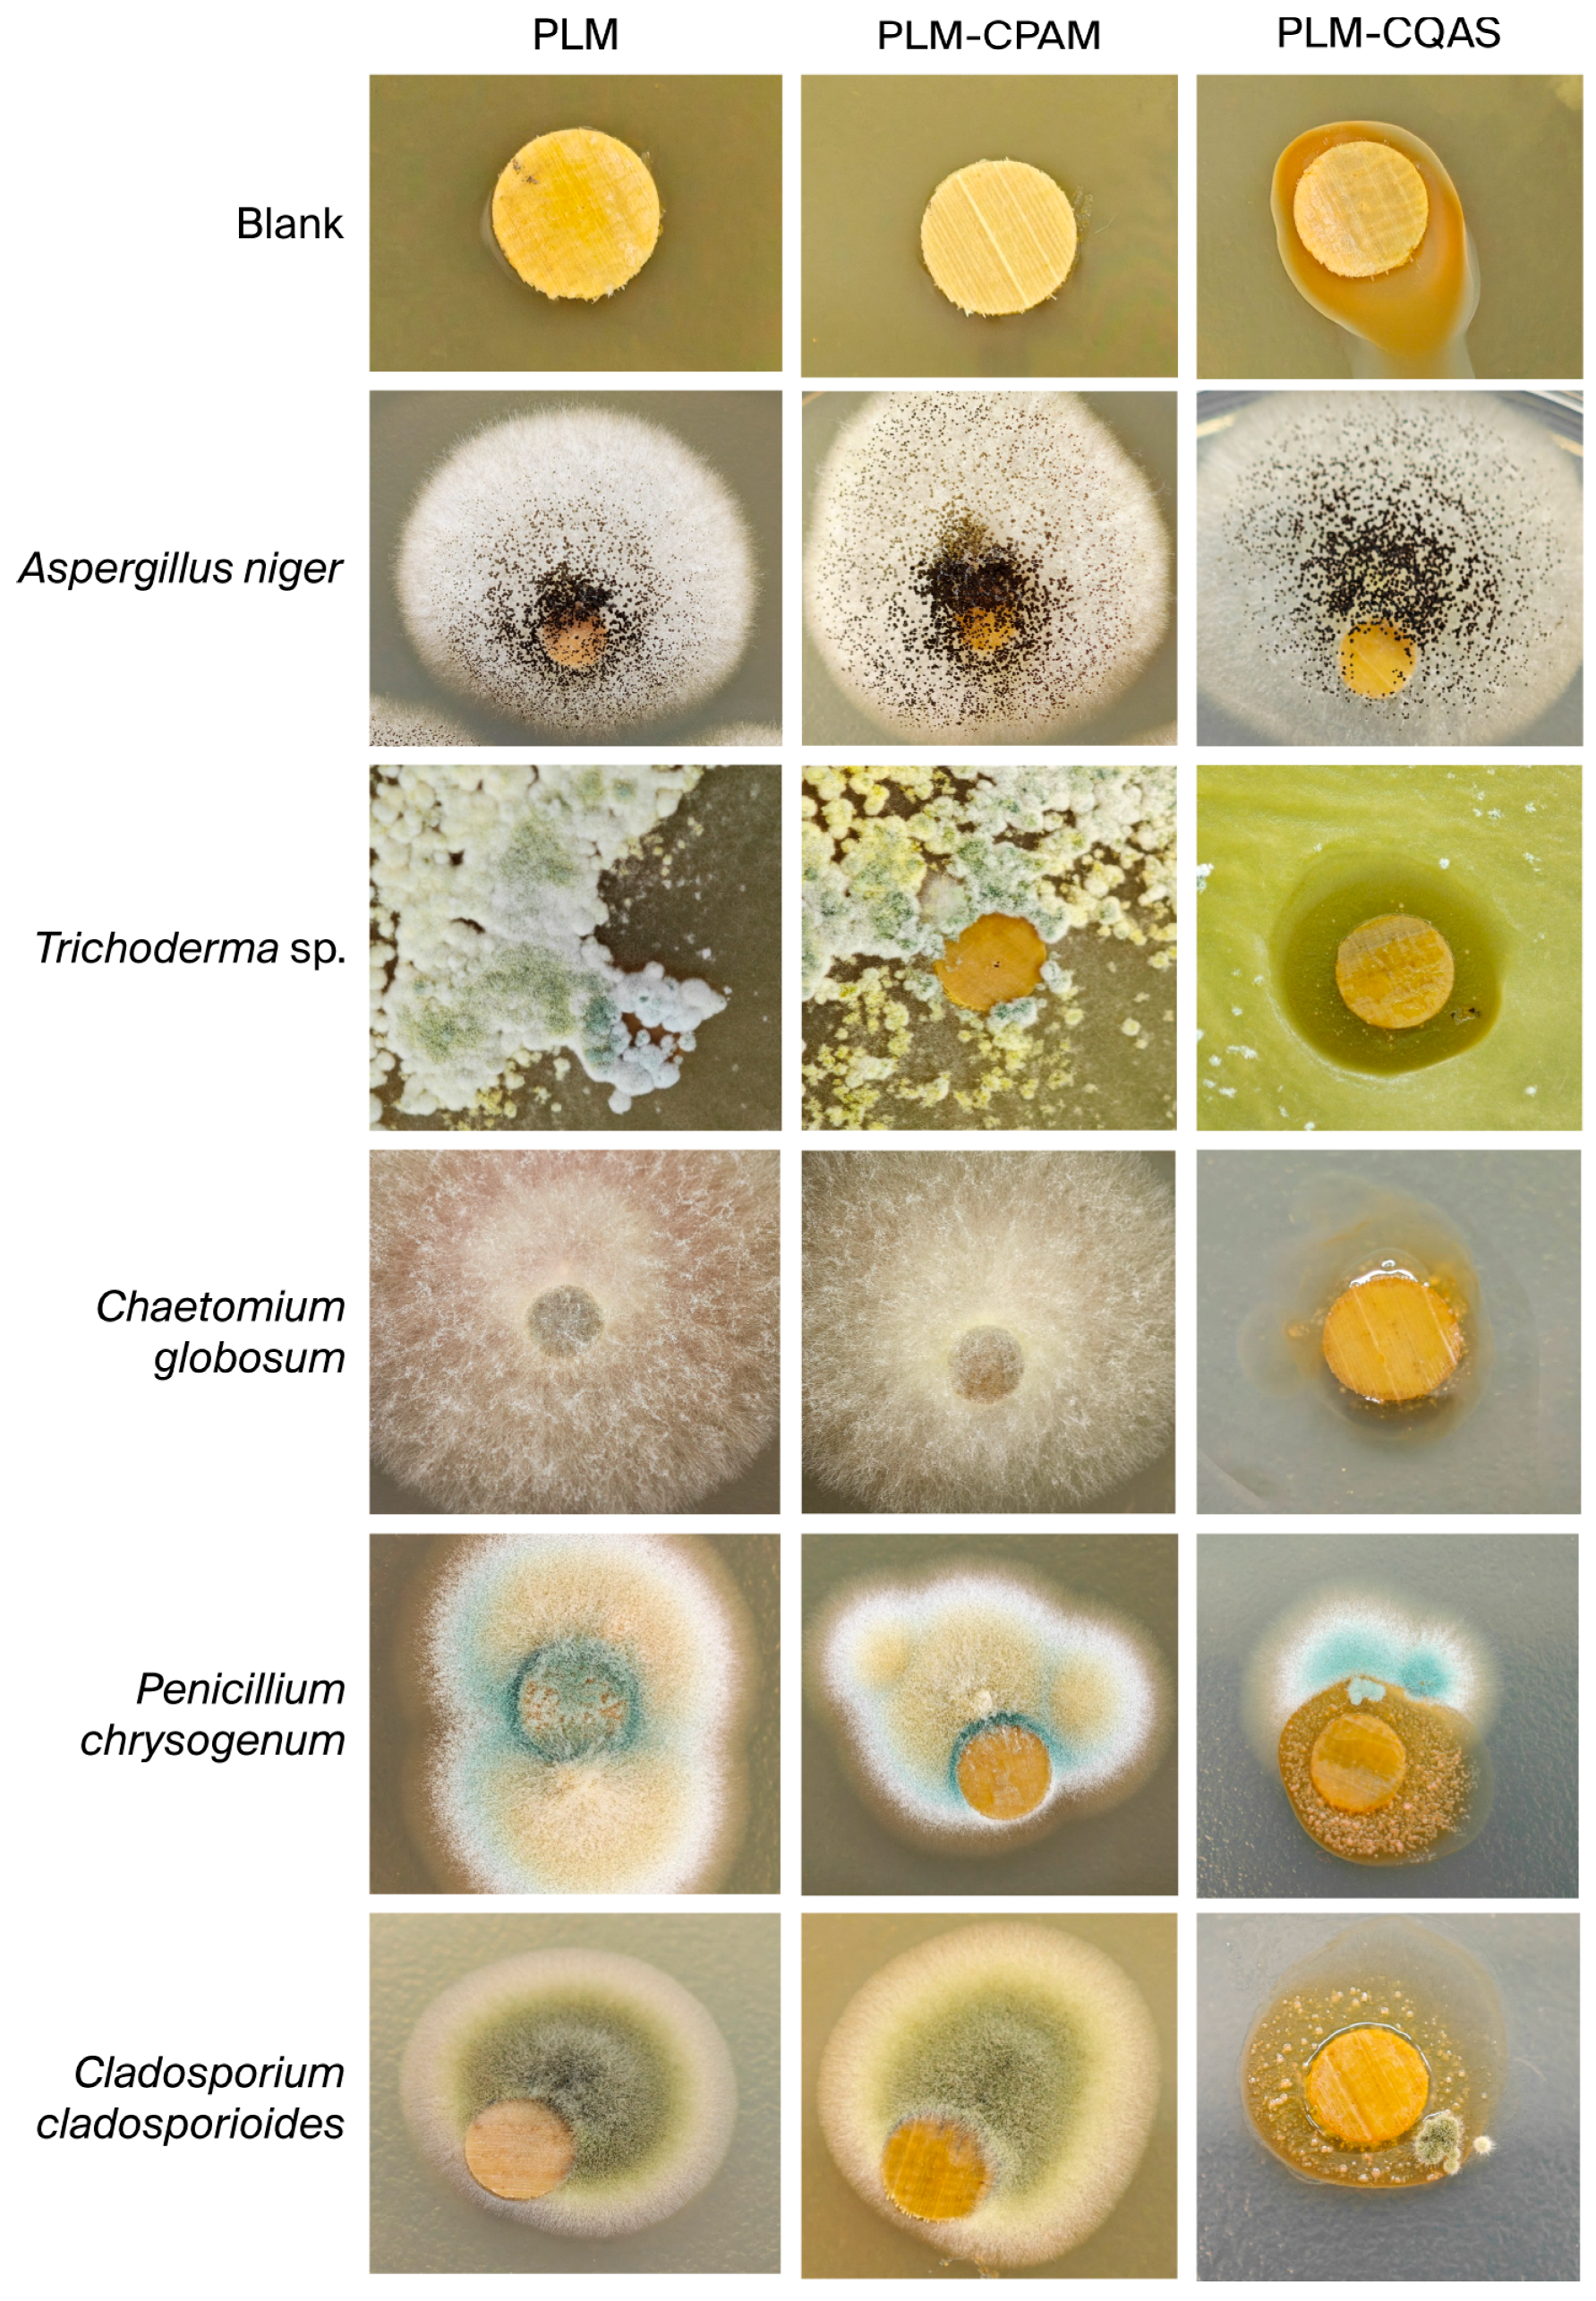
Coatings 15 01178 g008 Coatings 15 01178 g008

Enhancing the Durability of Palm-Leaf Manuscripts: A Comparative Study of CPAM and CQAS Encapsulation Materials
Abstract
1. Introduction
2. Materials and Methods
2.1. Materials
2.2. Aging Treatment
2.3. Microscope Observation
2.4. Color Measurements
2.5. Gloss Testing
2.6. Contact Angle Test
2.7. Determination of the pH Value
2.8. Scanning Electron Microscopy (SEM)
2.9. Tensile Strength Testing
2.10. Fourier Transform Infrared Spectra (FTIR)
2.11. Thermogravimetric Analysis (TGA)
2.12. Strains
2.13. Antifungal Assay
3. Results and Discussion
3.1. Surface Properties Analysis
3.2. Tensile Properties
3.3. FT-IR Analysis
3.4. Thermal Stability Analysis
3.5. Antifungal Performance Analysis
4. Conclusions
Supplementary Materials
Author Contributions
Funding
Institutional Review Board Statement
Informed Consent Statement
Data Availability Statement
Conflicts of Interest
References
- Wiland, J.; Brown, R.; Fuller, L.; Havelock, L.; Johnson, J.; Kenn, D.; Kralka, P.; Muzart, M.; Pollard, J.; Snowdon, J. A literature review of palm leaf manuscript conservation—Part 1: A historic overview, leaf preparation, materials and media, palm leaf manuscripts at the British Library and the common types of damage. J. Inst. Conserv. 2022, 45, 236–259. [Google Scholar] [CrossRef]
- Voges, L.F.; Horn, N.; Ciotti, G.; Seifert, S. Differentiation of Species and Provenance of Palm-Leaf Manuscripts Using Fourier Transform Infrared Spectroscopy and Chemometrics. Chemosensors 2025, 13, 196. [Google Scholar] [CrossRef]
- Yu, D.; Li, X.; Sun, S.a.; Guo, H.; Luo, H.; Zhu, J.; Li, L.; Wang, S.; Han, L. The effect of traditional processing craft on the hygroscopicity of palm leaf manuscripts. Herit. Sci. 2024, 12, 280. [Google Scholar] [CrossRef]
- Zhang, W.; Wang, S.; Guo, H. Study on the Effects of Temperature and Relative Humidity on the Hygroscopic Properties of Palm Leaf Manuscripts. Forests 2024, 15, 1816. [Google Scholar] [CrossRef]
- Yu, C.; Zhang, M.; Song, X. Analysis of Two Different Inks and Application Techniques on Palm Leaf Manuscripts Through Non-Invasive Analysis. Restaurator. Int. J. Preserv. Libr. Arch. Mater. 2024, 45, 237–256. [Google Scholar] [CrossRef]
- Sharma, D.; Singh, M.R.; Dighe, B. Chromatographic Study on Traditional Natural Preservatives Used for Palm Leaf Manuscripts in India. Restaurator. Int. J. Preserv. Libr. Arch. Mater. 2018, 39, 249–264. [Google Scholar] [CrossRef]
- Zhang, J.; Yu, H.; Li, Y.; Liu, P.; Huang, Y. Advances in Palm Leaf Manuscripts from a Biological Perspective. J. Fudan Univ. (Nat. Sci.) 2024, 63, 658–666. (In Chinese) [Google Scholar]
- Li, Y.; Zhang, J.; Qin, Y.; Li, Y.; Wu, S.; Yan, B.; Yu, H.; Xu, Q.; Liu, P.; Huang, Y.; et al. Scientific restoration of engraved palm leaf manuscripts. NPJ Herit. Sci. 2025, 13, 380. [Google Scholar] [CrossRef]
- Agrawal, O.P. Conservation of manuscripts and paintings of South-East Asia; Butterworth-Heinemann: London, 1984. [Google Scholar]
- Dyke, Y.V. Sacred leaves: The conservation and exhibition of early Buddhist manuscripts on palm leaves. Book Pap. Group Annu. 2009, 28, 83–97. [Google Scholar]
- Chu, S.; Lin, L.; Tian, X. Evaluation of the Deterioration State of Historical Palm Leaf Manuscripts from Burma. Forests 2023, 14, 1775. [Google Scholar] [CrossRef]
- Wiland, J.; Brown, R.; Fuller, L.; Havelock, L.; Johnson, J.; Kenn, D.; Kralka, P.; Muzart, M.; Pollard, J.; Snowdon, J. A literature review of palm leaf manuscript conservation—Part 2: Historic and current conservation treatments, boxing and storage, religious and ethical issues, recommendations for best practice. J. Inst. Conserv. 2023, 46, 64–91. [Google Scholar] [CrossRef]
- Nishanthi, M.; Wijayasundara, N.D. Preservation and Conservation of Palm Leaf Manuscripts at the Library of University of Sri Jayewardenepura. Vidyodaya J. Humanit. Soc. Sci. 2022, 7, 81–96. [Google Scholar] [CrossRef]
- Rachman, Y.B. The Use of Traditional Conservation Methods in the Preservation of Ancient Manuscripts: A Case Study from Indonesia. Preserv. Digit. Technol. Cult. 2017, 46, 109–115. [Google Scholar] [CrossRef]
- Suryawanshi, D.G.; Nair, M.V.; Sinha, P.M. Improving the Flexibility of Palm Leaf. Restaurator. Int. J. Preserv. Libr. Arch. Mater. 1992, 13, 37–46. [Google Scholar] [CrossRef]
- Joshi, B.R. Preservation of Palm Leaf Manuscripts. Conserv. Cult. Prop. 1989, 22, 120–127. [Google Scholar]
- Ding, J.; Yu, J.; Zhu, J.; Han, L.; Guo, H.; Feng, R.; Dong, W.; Zhao, X.; Wang, S.; Li, L.; et al. Exploring the Effects of Ionic Liquid on the Toughness of Palm Leaf Manuscripts. Langmuir 2025, 41, 1625–1638. [Google Scholar] [CrossRef]
- Sah, A. Palm Leaf manuscripts of the world: Material, technology and conservation. Stud. Conserv. 2002, 47, 15–24. [Google Scholar] [CrossRef]
- Chen, Y.; Li, J.; Li, Q.; Shen, Y.; Ge, Z.; Zhang, W.; Chen, S. Enhanced water-solubility, antibacterial activity and biocompatibility upon introducing sulfobetaine and quaternary ammonium to chitosan. Carbohydr. Polym. 2016, 143, 246–253. [Google Scholar] [CrossRef] [PubMed]
- Li, J.; Xie, B.; Xia, K.; Zhao, C.; Li, Y.; Li, D.; Han, J. Facile synthesis and characterization of cross-linked chitosan quaternary ammonium salt membrane for antibacterial coating of piezoelectric sensors. Int. J. Biol. Macromol. 2018, 120, 745–752. [Google Scholar] [CrossRef]
- Xue, Y.; Pan, Y.; Xiao, H.; Zhao, Y. Novel quaternary phosphonium-type cationic polyacrylamide and elucidation of dual-functional antibacterial/antiviral activity. RSC Adv. 2014, 4, 46887–46895. [Google Scholar] [CrossRef]
- Freeman, R. Turning Over Old Leaves: Palm Leaves Used in South Asian Manuscripts. Book Pap. Group Annu. 2005, 24, 99–102. [Google Scholar]
- Sharma, D.; Singh, M.; Krist, G.; Velayudhan, N.M. Structural Characterisation of 18TH Century Indian Palm Leaf Manuscripts of India. Int. J. Conserv. Sci. 2018, 9, 257–264. [Google Scholar]
- Panigrahi, A.K.; Litt, D. Odia script in palm-leaf manuscripts. IOSR J. Humanit. Soc. Sci. 2018, 23, 13–19. [Google Scholar]
- Ghosh, S.; Mahajan, A.; Banerjee, S. Palm leaf manuscript conservation, the process of seasoning with special reference to Saraswati Mahal library, Tamilnadu in India: Some techniques. Int. J. Inf. Mov. 2017, 122–128. [Google Scholar]
- Sahoo, J. A Selective Review of Scholarly Communications on Palm Leaf Manuscripts. Libr. Philos. Pract. 2016. [Google Scholar]
- Kumar, D.U.; Sreekumar, G.; Athvankar, U.A. Traditional Writing System in Southern India—Palm Leaf Manuscripts. Des. Thoughts 2009, 7, 2–7. [Google Scholar]
- GB/T 22894-2008; Paper and Board—Accelerated Ageing—Moist Heat Treatment at 80 Celsius and 65% Relative Humidity. National Standards of People’s Republic of China: Beijing, China, 2008.
- GB/T 13528–2015; Paper and Board—Determination of Surface pH. National Standards of People’s Republic of China: Beijing, China, 2015.
- Zhang, W.; Wang, S.; Han, L.; Guo, H. Aging effects of relative humidity on palm leaf manuscripts and optimal humidity conditions for preservation. NPJ Herit. Sci. 2025, 13, 218. [Google Scholar] [CrossRef]
- Zhao, H.; Liu, P.; Huang, Y.; Zhang, H. Nanocomposites composed of modified natural polymer and inorganic nanomaterial for safe, high-efficiency, multifunctional protection of paper-based relics. Sci. China Technol. Sci. 2023, 66, 2225–2236. [Google Scholar] [CrossRef]
- Cheng, Z.; Li, J.; He, G.; Su, M.; Xiao, N.; Zhang, X.; Zhong, L.; Wang, H.; Zhong, Y.; Chen, Q.; et al. Biodegradable packaging paper derived from chitosan-based composite barrier coating for agricultural products preservation. Int. J. Biol. Macromol. 2024, 280, 136112. [Google Scholar] [CrossRef]
- Takushi, S.; Tatsuo, Y. Strength properties of paper containing polyacrylamide-based dry strength resin-effect of its Z-directional distribution. APPITA J. 2011, 64, 331–337. [Google Scholar]
- Nikkhah Dafchahi, M.; Resalati, H.; Zabihzadeh, S.M.; Nazarnezhad, N.; Asadpour, G.; Pirayesh, H. Novel calcium carbonate filler for cellulose industry. Nord. Pulp Pap. Res. J. 2021, 36, 536–547. [Google Scholar] [CrossRef]
- Tang, Z.; Yang, M.; Qiang, M.; Li, X.; Morrell, J.J.; Yao, Y.; Su, Y. Preparation of Cellulose Nanoparticles from Foliage by Bio-Enzyme Methods. Materials 2021, 14, 4557. [Google Scholar] [CrossRef]
- Fang, S.; Lyu, X.; Tong, T.; Lim, A.I.; Li, T.; Bao, J.; Hu, Y.H. Turning dead leaves into an active multifunctional material as evaporator, photocatalyst, and bioplastic. Nat. Commun. 2023, 14, 1203. [Google Scholar] [CrossRef]
- Jayaramudu, J.; Jeevan Prasad Reddy, D.; Guduri, B.R.; Varada Rajulu, A. Properties of natural fabric polyalthia cerasoides. Fibers Polym. 2009, 10, 338–342. [Google Scholar] [CrossRef]
- Zhang, W.; Wang, S.; Guo, H. Study on the Aging Effects of Relative Humidity on the Primary Chemical Components of Palm Leaf Manuscripts. Polymers 2025, 17, 83. [Google Scholar] [CrossRef] [PubMed]
- AlMaadeed, M.A.; Kahraman, R.; Noorunnisa Khanam, P.; Al-Maadeed, S. Characterization of untreated and treated male and female date palm leaves. Mater. Des. 2013, 43, 526–531. [Google Scholar] [CrossRef]
- Kayabas, A.; Yildirim, E. Biochemical Fingerprints of Some Endemic Plants Growing in Gypsum Soils: Attenuated Total Reflection-Fourier Transform Infrared (ATR-FTIR) Spectroscopic Study. Eur. J. Biol. 2021, 80, 97–106. [Google Scholar] [CrossRef]
- Mahdi, A.S.; Abd, A.M.; Awad, K.M. The Role of Nano-selenium in Alleviating the Effects of Salt Stress in Date Palm Trees (Phoenix dactylifera L.): A Fourier Transform Infrared (FTIR) Spectroscopy Study. BioNanoScience 2023, 13, 74–80. [Google Scholar] [CrossRef]
- Chu, S.; Lin, L.; Tian, X. Analysis of Aspergillus niger isolated from ancient palm leaf manuscripts and its deterioration mechanisms. Herit. Sci. 2024, 12, 199. [Google Scholar] [CrossRef]
- Traoré, M.; Kaal, J.; Martínez Cortizas, A. Application of FTIR spectroscopy to the characterization of archeological wood. Spectrochim. Acta Part A Mol. Biomol. Spectrosc. 2016, 153, 63–70. [Google Scholar] [CrossRef] [PubMed]
- Lazić, B.D.; Pejić, B.M.; Kramar, A.D.; Vukčević, M.M.; Mihajlovski, K.R.; Rusmirović, J.D.; Kostić, M.M. Influence of hemicelluloses and lignin content on structure and sorption properties of flax fibers (Linum usitatissimum L.). Cellulose 2018, 25, 697–709. [Google Scholar] [CrossRef]
- Wang, P.; Pang, J.; Zhang, H.; Liao, H.; Xiong, D.; Zhu, L.; Xue, D.; You, M.; Liu, Y.; Li, J.; et al. Composition, structural, and thermal analysis of cellulose, hemicellulose, and lignin of reconstituted cut stems in tobacco. Ind. Crops Prod. 2024, 222, 119614. [Google Scholar] [CrossRef]
- Ivanova, D.G.; Singh, B.R. Nondestructive FTIR monitoring of leaf senescence and elicitin-induced changes in plant leaves. Biopolymers 2003, 72, 79–85. [Google Scholar] [CrossRef]
- Zhang, T.; Guo, M.; Cheng, L.; Li, X. Investigations on the structure and properties of palm leaf sheath fiber. Cellulose 2015, 22, 1039–1051. [Google Scholar] [CrossRef]
- Schwanninger, M.; Rodrigues, J.C.; Pereira, H.; Hinterstoisser, B. Effects of short-time vibratory ball milling on the shape of FT-IR spectra of wood and cellulose. Vib. Spectrosc. 2004, 36, 23–40. [Google Scholar] [CrossRef]
- He, Z.; Qian, J.; Qu, L.; Yan, N.; Yi, S. Effects of Tung oil treatment on wood hygroscopicity, dimensional stability and thermostability. Ind. Crops Prod. 2019, 140, 111647. [Google Scholar] [CrossRef]
- Marchessault, R.H. Application of infra-red spectroscopy to cellulose and wood polysaccharides. Pure Appl. Chem. 1962, 5, 107–130. [Google Scholar] [CrossRef]
- Feng, L.; Zheng, H.; Gao, B.; Zhao, C.; Zhang, S.; Chen, N. Enhancement of textile-dyeing sludge dewaterability using a novel cationic polyacrylamide: Role of cationic block structures. RSC Adv. 2017, 7, 11626–11635. [Google Scholar] [CrossRef]
- Sun, J.; Ma, X.; Li, X.; Fan, J.; Chen, Q.; Liu, X.; Pan, J. Preparation of a cationic polyacrylamide (CPAM) and its flocculation performance in the environmental estrogen removal and separation. Desalination Water Treat. 2017, 100, 231–242. [Google Scholar] [CrossRef]
- Sun, W.; Zhang, G.; Pan, L.; Li, H.; Shi, A. Synthesis, Characterization, and Flocculation Properties of Branched Cationic Polyacrylamide. Int. J. Polym. Sci. 2013, 2013, 397027. [Google Scholar] [CrossRef]
- Zhao, C.; Zheng, H.; Sun, Y.; Zhang, S.; Liang, J.; Liu, Y.; An, Y. Evaluation of a novel dextran-based flocculant on treatment of dye wastewater: Effect of kaolin particles. Sci. Total Environ. 2018, 640–641, 243–254. [Google Scholar] [CrossRef]
- Gao, M.; Yang, Y.L.; Xu, Z.Q. Preparation of Cationic Polyacrylamide Flocculant and its Application in the Treatment of Coal Slurry Wastewater. Adv. Mater. Res. 2012, 560–561, 591–594. [Google Scholar] [CrossRef]
- Yue, L.; Li, J.; Chen, W.; Liu, X.; Jiang, Q.; Xia, W. Geraniol grafted chitosan oligosaccharide as a potential antibacterial agent. Carbohydr. Polym. 2017, 176, 356–364. [Google Scholar] [CrossRef]
- Zhang, J.; Tan, W.; Li, Q.; Liu, X.; Guo, Z. Preparation of Cross-linked Chitosan Quaternary Ammonium Salt Hydrogel Films Loading Drug of Gentamicin Sulfate for Antibacterial Wound Dressing. Mar. Drugs 2021, 19, 479. [Google Scholar] [CrossRef]
- Rodríguez-Núñez, J.R.; Madera-Santana, T.J.; Sánchez-Machado, D.I.; López-Cervantes, J.; Soto Valdez, H. Chitosan/Hydrophilic Plasticizer-Based Films: Preparation, Physicochemical and Antimicrobial Properties. J. Polym. Environ. 2014, 22, 41–51. [Google Scholar] [CrossRef]
- Barbosa, H.F.G.; Francisco, D.S.; Ferreira, A.P.G.; Cavalheiro, É.T.G. A new look towards the thermal decomposition of chitins and chitosans with different degrees of deacetylation by coupled TG-FTIR. Carbohydr. Polym. 2019, 225, 115232. [Google Scholar] [CrossRef] [PubMed]
- Peng, Z.-X.; Wang, L.; Du, L.; Guo, S.-R.; Wang, X.-Q.; Tang, T.-T. Adjustment of the antibacterial activity and biocompatibility of hydroxypropyltrimethyl ammonium chloride chitosan by varying the degree of substitution of quaternary ammonium. Carbohydr. Polym. 2010, 81, 275–283. [Google Scholar] [CrossRef]
- Mauricio-Sánchez, R.A.; Salazar, R.; Luna-Bárcenas, J.G.; Mendoza-Galván, A. FTIR spectroscopy studies on the spontaneous neutralization of chitosan acetate films by moisture conditioning. Vib. Spectrosc. 2018, 94, 1–6. [Google Scholar] [CrossRef]
- Xing, H.; Wang, J.; Ma, O.; Chao, X.; Zhou, Y.; Li, Y.; Jia, Z. Hydroxypropyltrimethyl Ammonium Chloride Chitosan Nanoparticles Coatings for Reinforcement and Concomitant Inhibition of Anionic Water-Sensitive Dyes Migration on Fragile Paper Documents. Polymers 2022, 14, 3717. [Google Scholar] [CrossRef]
- Apaydın Varol, E.; Mutlu, Ü. TGA-FTIR Analysis of Biomass Samples Based on the Thermal Decomposition Behavior of Hemicellulose, Cellulose, and Lignin. Energies 2023, 16, 3674. [Google Scholar] [CrossRef]
- Nechita, P.; Bobu, E.; Parfene, G.; Dinică, R.M.; Bălan, T. Antimicrobial coatings based on chitosan derivatives and quaternary ammonium salts for packaging paper applications. Cellul. Chem. Technol. 2015, 49, 625–632. [Google Scholar]
- Zhang, W.; Zhou, J.; Dai, X. Preparation and characterization of reactive chitosan quaternary ammonium salt and its application in antibacterial finishing of cotton fabric. Text. Res. J. 2017, 87, 759–765. [Google Scholar] [CrossRef]
- Liu, N.; Chu, D.; Chen, X.; Fu, P.; Xing, H.; Chao, X.; Luo, Y.; Mai, B.; Li, Y. A Spray-On Microemulsion with Mold-Proof Effect on Paper. Coatings 2023, 13, 745. [Google Scholar] [CrossRef]

Disclaimer/Publisher’s Note: The statements, opinions and data contained in all publications are solely those of the individual author(s) and contributor(s) and not of MDPI and/or the editor(s). MDPI and/or the editor(s) disclaim responsibility for any injury to people or property resulting from any ideas, methods, instructions or products referred to in the content. |
© 2025 by the authors. Licensee MDPI, Basel, Switzerland. This article is an open access article distributed under the terms and conditions of the Creative Commons Attribution (CC BY) license (https://creativecommons.org/licenses/by/4.0/).
Share and Cite
Wu, S.; Li, Y.; Zhang, J.; Yu, H.; Lin, R.; Yu, H.; Liu, P.; Huang, Y. Enhancing the Durability of Palm-Leaf Manuscripts: A Comparative Study of CPAM and CQAS Encapsulation Materials. Coatings 2025, 15, 1178. https://doi.org/10.3390/coatings15101178
Wu S, Li Y, Zhang J, Yu H, Lin R, Yu H, Liu P, Huang Y. Enhancing the Durability of Palm-Leaf Manuscripts: A Comparative Study of CPAM and CQAS Encapsulation Materials. Coatings. 2025; 15(10):1178. https://doi.org/10.3390/coatings15101178
Chicago/Turabian StyleWu, Shixun, Yan Li, Jingyu Zhang, Hanwei Yu, Ruiyao Lin, Hui Yu, Peng Liu, and Yanyan Huang. 2025. "Enhancing the Durability of Palm-Leaf Manuscripts: A Comparative Study of CPAM and CQAS Encapsulation Materials" Coatings 15, no. 10: 1178. https://doi.org/10.3390/coatings15101178
APA StyleWu, S., Li, Y., Zhang, J., Yu, H., Lin, R., Yu, H., Liu, P., & Huang, Y. (2025). Enhancing the Durability of Palm-Leaf Manuscripts: A Comparative Study of CPAM and CQAS Encapsulation Materials. Coatings, 15(10), 1178. https://doi.org/10.3390/coatings15101178

